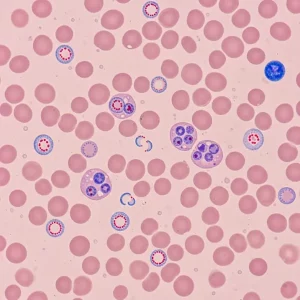
Malarial Smear

Blood
Showing 65–80 of 125 results
-

hsCRP
₱1,100.00 Book now -

HSV 1 & 2 ELISA IgG
₱3,200.00 Book now -

HSV 1 & 2 ELISA IgM
₱3,200.00 Book now -

Ionized Calcium
₱800.00 Book now -

Iron
₱800.00 Book now -

LDH
₱900.00 Book now -

LDL
₱450.00 Book now -

LE Prep
₱450.00 Book now -

Leptospira (IgG & IgM)
₱1,300.00 Book now -

LH
₱1,200.00 Book now -

Lipase
₱600.00 Book now -

Lipid Profile
₱1,500.00 Book now -

Magnesium
₱600.00 Book now -

Malarial Smear
₱450.00 Book now -

Paratyhyroid Hormone (7 days)
₱4,500.00 Book now -

Peripheral Smear
₱450.00 Book now